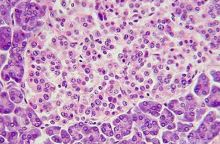

发布时间:2024-12-26 浏览:292次
国际糖尿病联盟发布的数据显示,截至2021年,在全球糖尿病患者最多的中国,有超过1.4亿的糖尿病患者。
2型糖尿病患者约占国内糖尿病患者的9成,它是一种在遗传和环境因素下,导致胰岛素抵抗和胰岛β细胞损伤造成的疾病,典型病状是“三多一少”:多尿、烦渴、多食,体重减轻。
2型糖尿病是人类社会重要的健康问题之一,2型糖尿病需要长期服药,治疗周期长且易产生并发症,给医疗卫生系统带来了巨大压力。
近年来的研究证实,肠道微生物群影响宿主能量代谢且与2型糖尿病发病机制密切相关,作为肠道微生物群衍生物的短链脂肪酸(SCFAs)在这种联系中发挥了重要作用。临床研究发现,SCFAs可改善2型糖尿病患者的血糖、体质量及胰岛素抵抗(IR),并提高葡萄糖耐量。
SCFAs主要包括乙酸、丙酸和丁酸。SCFAs的底物主要是膳食纤维和蛋白质,这些物质在发酵产生SCFAs的过程中为宿主提供能量。SCFAs主要产生于肠道,多个菌种参与这一过程,是其外源性来源。细胞代谢过程中的脂肪酸氧化也会产生SCFAs,是其内源性来源。

SCFAs在2型糖尿病中的作用
01 调节食欲
胰高血糖素样肽-1(GLP-1)和肽酪氨酸主要由肠L细胞产生,二者可减少饮食摄入。
动物实验发现,SCFAs可以刺激肠L细胞分泌GLP-1,通过激活迷走神经中的GLP-1受体诱导下丘脑产生饱腹感信号。GLP-1可以增强葡萄糖刺激的胰岛素分泌(GSIS)从而降低葡萄糖的循环水平,同时还抑制胰高血糖素分泌从而减少内源性葡萄糖的产生,达到减少食物摄入和减慢胃排空的效果。
瘦素通过抑制外侧下丘脑含有表达黑色素浓缩激素和食欲素的神经元来减少饮食摄入。有研究表明,SCFAs可通过激活游离脂肪酸受体2和游离脂肪酸受体3来刺激瘦素的表达。

02 调节炎症
肠道作为一个半渗透的物理屏障,可以限制细菌和分子的渗透。2型糖尿病患者存在显著的肠道微生物群失调,导致肠粘膜屏障受损,使脂多糖不断渗入血液中,引发炎症。
SCFAs则可以通过维持肠道屏障功能和对免疫细胞及炎性因子的调节来缓解炎症状态,对改善2型糖尿病具有积极意义。
丁酸作为结肠细胞的主要能量来源,对于维持结肠稳态具有重要意义。丁酸钠通过促进上皮细胞增殖以及增加肠内膜紧密连接蛋白如occludin和zona occludens-1的表达来维持肠道屏障的完整性,还可促进转录因子SP1与Claudin-1启动子之间的相互作用来增加Claudin-1转录,增强肠道屏障功能。
03 调节胰岛 β 细胞
胰岛β细胞在调节血糖、维持葡萄糖稳态中发挥着重要作用。2型糖尿病患者常有胰岛β细胞功能障碍, 这可能是炎症和代谢功能受损的应激表现,维持或改善β细胞的功能和状态是治疗2型糖尿病的主要目标之一。
动物实验结果显示,丁酸盐可以促进胰岛素基因表达的显著上升和β细胞数量的增加。实验发现SCFAs以浓度依赖性的方式影响人类胰岛细胞的活力,1 mmol/L 和 2 mmol/L 的乙酸和丁酸可以预防β细胞凋亡,并通过支持线粒体呼吸功能,防止β细胞耗氧率的降低。
04 改善骨骼肌IR
骨骼肌胰岛素抵抗是2型糖尿病的重要特征,也是评价2型糖尿病严重程度的指标之一,导致这一现象的原因主要有线粒体功能障碍、糖原合成受损及胰岛素信号传导受损。
运动是2型糖尿病的治疗措施之一,通过增加能量消耗,减少脂质累积改善2型糖尿病的症状。有研究探讨了运动对骨骼肌胰岛素抵抗的影响,发现运动对2型糖尿病模型大鼠的肠道微生物群分布产生影响,从而逆转了SCFAs的减少。
SCFAs通过多个途径改善骨骼肌胰岛素抵抗,这对于维持机体的胰岛素受体质量与数量,保证正常糖摄取,从而缓解2型糖尿病具有重要意义。
05
调节脂质代谢
SCFAs不仅可以作为底物参与脂质代谢,同时还可作为调节因子影响脂质代谢。
l 乙酸盐可以抑制肝脏、骨骼肌和脂肪组织中的脂质沉积。
l 丙酸盐可以降低腹部脂肪的分布以及肝脏中的脂质含量。
l 丁酸与脂肪组织中的GPR109a受体结合可以增加脂质氧化和能量消耗,减少脂质沉积。
形态测量分析显示,高脂饮食培养60天后,动物模型中会出现脂质沉积状态的肝细胞,占全部肝细胞的21%。通过饮食补充丁酸盐不仅将产生脂质沉积的肝细胞比例降低到11%,同时还可减少细胞质脂滴的大小和比例。
在2型糖尿病模型大鼠中同样观察到了丁酸减轻肝脏脂质沉积的结果。这种结果可能与SCFAs增加能量消耗,增强线粒体功能并促进脂肪酸氧化有关。
与白色脂肪相比,褐色脂肪能够产生更多的热量,消耗更多的能量。促进白色脂肪褐变是调节脂质代谢和减轻肥胖的措施之一。
如前文所述,SCFAs可以提高瘦素的表达,瘦素作用于下丘脑后,通过交感神经刺激去甲肾上腺素的分泌。去甲肾上腺素作用于白色脂肪上的β3肾上腺素受体促进白色脂肪褐变。因此,提高SCFAs的表达水平可以促进白色脂肪褐变,是调节脂质代谢的方式之一。

参考文献:
1.CANFORA E E, MEEX R C R, VENEMA K, et al. Gut microbial metabolites in obesity, NAFLD and T2DM [J]. Nat Rev Endocrinol, 2019, 15(5): 261-273. DOI: 10.1038/s41574-019-0156-z.
2.VITALE M, GIACCO R, LAIOLA M, et al. Acute and chronic improvement in postprandial glucose metabolism by a diet resembling the traditional Mediterranean dietary pattern: can SCFAs play a role? [J]. Clin Nutr, 2021, 40(2): 428-437. DOI: 10.1016/j.clnu.2020.05.025.
3.PALACIOS T, VITETTA L, COULSON S, et al. Targeting the intestinal microbiota to prevent type 2 diabetes and enhance the effect of metformin on glycaemia: a randomised controlled pilot study [J]. Nutrients, 2020, 12(7): 2041. DOI: 10.3390/nu12072041.
4.YADAV H, LEE J H, LLOYD J, et al. Beneficial metabolic effects of a probiotic via butyrate-induced GLP-1 hormone secretion [J]. J Biol Chem, 2013, 288(35): 25088-25097. DOI: 10.1074/jbc.M113.452516.
5.HE J, ZHANG P W, SHEN L Y, et al. Short-chain fatty acids and their association with signalling pathways in inflammation, glucose and lipid metabolism [J]. Int J Mol Sci, 2020, 21(17): 6356. DOI: 10.3390/ijms21176356.
6.MACFARLANE G T, MACFARLANE S. Bacteria, colonic fermentation, and gastrointestinal health [J]. J AOAC Int, 2012, 95(1): 50-60. DOI: 10.5740/jaoacint.sge_macfarlane.
7.FREELAND K R, WILSON C, WOLEVER T M S. Adaptation of colonic fermentation and glucagon-like peptide-1 secretion with increased wheat fibre intake for 1 year in hyperinsulinaemic human subjects [J]. Br J Nutr, 2010, 103(1): 82-90. DOI: 10.1017/S0007114509991462.
8.MURPHY K G, BLOOM S R. Gut hormones and the regulation of energy homeostasis [J]. Nature, 2006, 444(7121): 854-859. DOI: 10.1038/nature05484.
9.DELZENNE N, BLUNDELL J, BROUNS F, et al. Gastrointestinal targets of appetite regulation in humans [J]. Obes Rev, 2010, 11(3): 234-50. [37] DALAMAGA M, CHOU S H, SHIELDS K, et al. Leptin at the intersection of neuroendocrinology and metabolism: current evidence and therapeutic perspectives [J]. Cell metabolism, 2013, 18(1): 29-42.
10.KIMURA I, OZAWA K, INOUE D, et al. The gut microbiota suppresses insulin-mediated fat accumulation via the short-chain fatty acid receptor GPR43 [J]. Nature Communications, 2013, 4: 1829.
11.SOHAIL M U, ALTHANI A, ANWAR H, et al. Role of the gastrointestinal tract microbiome in the pathophysiology of diabetes mellitus [J]. J Diabetes Res, 2017, 2017: 9631435. DOI: 10.1155/2017/9631435.
12.KUSHWAHA V, RAI P, VARSHNEY S, et al. Sodium butyrate reduces endoplasmic reticulum stress by modulating CHOP and empowers favorable anti-inflammatory adipose tissue immune-metabolism in HFD fed mice model of obesity [J]. Food Chem, 2022, 4: 100079. DOI: 10.1016/j.fochms.2022.100079.
13.WANG H B, WANG P Y, WANG X, et al. Butyrate enhances intestinal epithelial barrier function via up-regulation of tight junction protein Claudin-1 transcription [J]. Dig Dis Sci, 2012, 57(12): 3126-3135. DOI: 10.1007/s10620-012-2259-4.
14.HU S X, KUWABARA R, DE HAAN B J, et al. Acetate and butyrate improve β-cell metabolism and mitochondrial respiration under oxidative stress [J]. Int J Mol Sci, 2020, 21(4): 1542. DOI: 10.3390/ijms21041542.
15.BOON J, HOY A J, STARK R, et al. Ceramides contained in LDL are elevated in type 2 diabetes and promote inflammation and skeletal muscle insulin resistance [J]. Diabetes, 2013, 62(2): 401-410. DOI: 10.2337/db12-0686.
16.YAMASHITA H, MARUTA H, JOZUKA M, et al. Effects of acetate on lipid metabolism in muscles and adipose tissues of type 2 diabetic Otsuka Long-Evans Tokushima Fatty (OLETF) rats [J]. Biosci Biotechnol Biochem, 2009, 73(3): 570-576. DOI: 10.1271/bbb.80634.
17.CHAMBERS E S, VIARDOT A, PSICHAS A, et al. Effects of targeted delivery of propionate to the human colon on appetite regulation, body weight maintenance and adiposity in overweight adults [J]. Gut, 2015, 64(11): 1744-1754. DOI: 10.1136/gutjnl-2014-307913.
18.AHMED K, TUNARU S, OFFERMANNS S. GPR109A, GPR109B and GPR81, a family of hydroxy-carboxylic acid receptors [J]. Trends Pharmacol Sci, 2009, 30(11): 557-562. DOI: 10.1016/j.tips.2009.09.001.
19.WILLEBRORDS J, PEREIRA I V, MAES M, et al. Strategies, models and biomarkers in experimental non-alcoholic fatty liver disease research [J]. Prog Lipid Res, 2015, 59: 106-125. DOI: 10.1016/j.plipres.2015.05.002.
20.MATHEUS V A, MONTEIRO L, OLIVEIRA R B, et al. Butyrate reduces high-fat diet-induced metabolic alterations, hepatic steatosis and pancreatic beta cell and intestinal barrier dysfunctions in prediabetic mice [J]. Exp Biol Med, 2017, 242(12): 1214-1226. DOI: 10.1177/1535370217708188.
21.KHAN S, JENA G. Sodium butyrate reduces insulin-resistance, fat accumulation and dyslipidemia in type-2 diabetic rat:a comparative study with metformin [J]. Chem Biol Interact, 2016, 254: 124-134. DOI: 10.1016/j.cbi.2016.06.007.
22.DENG M J, QU F, CHEN L, et al. SCFAs alleviated steatosis and inflammation in mice with NASH induced by MCD [J]. J Endocrinol, 2020, 245(3): 425-437. DOI: 10.1530/JOE-20-0018.
23.CARON A, LEE S, ELMQUIST J K, et al. Leptin and brain-adipose crosstalks [J]. Nat Rev Neurosci, 2018, 19(3): 153-165. DOI:10.1038/nrn.2018.7.
#酒局守护神 #酉神1号 #酉神一号 #酉神壹号 #酒神1号 #酒神一号 #酒神壹号 #酉神1号解酒液 #酉神1号有机酸解酒液





